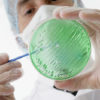
bacteries_intestin

- Accueil
- Livres
-

À cœur ouvert
10.00 € acheter ce livre -

JE PERDS MES CHEVEUX. Comment les retrouver ?
10.00 € Acheter ce livre -

Les bienfaits du lait de jument
8.00 € Acheter ce livre -

Antoine Béchamp, la compréhension du vivant
10.00 € Acheter ce livre -

Plantes fermentées effets santé décuplés
10.00 € Acheter ce livre -

COVID-19 : crise sanitaire ou crise sociétale ?
8.00 € Acheter ce livre -

COVID-19 : Vertrauenswürdige Experten und Minister ?
Laden Sie das Buch herunter -

DES TORTUES JUSQU’EN BAS (1er chapitre du livre éponyme)
7.50 € Acheter ce livre
-
- Blog
- Auteurs
- Pathologies
- Thématiques
- Conférences
- Covid-19
- TousAction en justiceConvoi de la liberté (Canada)Covid l’autre bout de la lorgnetteEconomieEffets secondairesHumourLa lettre de SentaLes filmsManifestationsMasquesMédecins suspendusMorts subites suite à la vaccination CovidOmicronPass et mesures sanitairesPolitiqueTest PCRVaccin Covid de l’autre côté du miroir
Découvrez des articles de qualité, rares et pointus, ainsi que de nombreux conseils multidisciplinaires (alimentation, compléments alimentaires, technologies…) rédigés et partagés par des professionnels de la santé (médecins, cancérologues, docteurs en sciences, diététiciens…) afin d'optimiser votre hygiène de vie et votre santé au quotidien.
C'est également une maison d'édition contenant une vaste collection de livres “Poche” exclusivement dédiés aux thèmes santé (certains livres sont téléchargeables gratuitement via PDF, Kindle ou Itunes).
Des outils de formation santé (vidéo-formations et conférences gratuites).
C'est également une maison d'édition contenant une vaste collection de livres “Poche” exclusivement dédiés aux thèmes santé (certains livres sont téléchargeables gratuitement via PDF, Kindle ou Itunes).
Des outils de formation santé (vidéo-formations et conférences gratuites).
Contactez-nous: info@medicatrix.be
© Medicatrix est une division des Editions marco pietteur sprlu